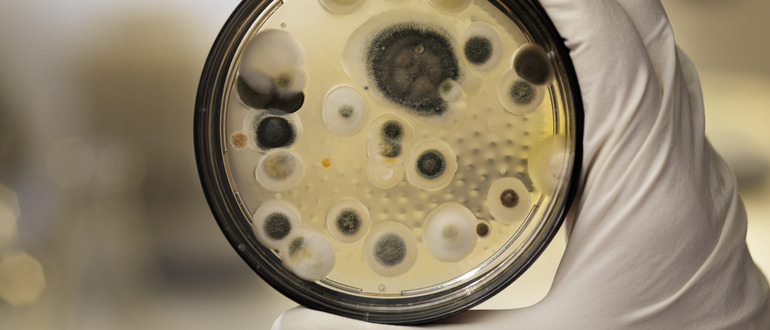

Muffa da condensa: soluzioni con riscaldamento e ventilazione
Muffa da condensa: soluzioni con riscaldamento e ventilazione
- Blog
- Esperto - Tecnico
Eliminare la condensa sui vetri, sul pavimento e sui muri
Come? Con il giusto riscaldamento e la giusta ventilazione
La muffa non si verifica solo nelle vecchie mura. La muffa può colpire anche nelle nuove costruzioni. In presenza di umidità, il fungo peloso può germogliare. La colpa è degli abitanti della casa per non aver fatto uscire abbastanza aria dall'edificio? Architetti che progettano in modo errato? O artigiani negligenti?
L'angolo della stanza comincia a scurirsi e la macchia cresce rapidamente. Profuma, irrita le vie respiratorie, è velenoso e mette in pericolo la salute. Anche il tessuto dell'edificio ne soffre: La muffa può fare grandi danni.
Di chi è la colpa?
Chiaramente, i residenti respirano, sudano, fanno la doccia, cucinano e si lavano. In poche parole, rilasciano costantemente umidità che deve depositarsi da qualche parte. "Ma è tutto perfettamente normale", afferma Mag. Brigitte Tassenbacher. Il microbiologo e tecnico ambientale si occupa di ingegneria delle costruzioni e dei servizi edilizi ad alta efficienza energetica e ha molti anni di esperienza come esperto di muffe certificato. Viene spesso consultata come perito in cause giudiziarie.
Se la temperatura e l'umidità sono misurate al centro di un ambiente, i valori sono di solito all'interno del range normale e quindi non sono pericolosi: la temperatura ambiente è di circa 20 °C, l'umidità relativa è di circa il 50-55%. D'altra parte, se la temperatura viene misurata sulla superficie di un componente dell'edificio, ad esempio in un angolo esterno dell'edificio, la temperatura può facilmente scendere a 12 °C e più in basso. L'umidità relativa in questo punto è quindi pari o superiore all'80%. Questo crea le condizioni per la crescita della muffa.
Cosa può fare il progettista

Cosa può fare l'artigiano
La qualità della direzione lavori e dell'esecuzione è altrettanto importante anche dopo la progettazione. Secondo Brigitte Tassenbacher, gli errori sono particolarmente frequenti quando l'involucro dell'edificio è a tenuta d'aria. Se l'elettricista o l'installatore non sigilla le aperture, le tubazioni, i cavi, le prese e i collegamenti, o non li sigilla con cura, l'aria calda e umida dell'ambiente può penetrare nei componenti. "Questo crea le condizioni per l'accumulo di umidità, i danni all'edificio e la crescita di funghi".
Un esempio della ricca esperienza pratica di Brigitte Tassenbacher: Una trave di legno su una tettoia era infestata da muffa. Le sue ricerche hanno portato all'installazione ermetica di un apparecchio LED che illuminava una nicchia nella doccia. Il fatto che la muffa non si sviluppi sulla "scena del crimine", ma altrove è abbastanza comune e può essere attribuito a diverse condizioni di pressione. Anche se il materiale sfuso aggiunto per costruire la struttura del suolo è troppo umido, questo può aggiungere umidità a un edificio e portare in seguito alla muffa.
Come può intervenire l'amministrazione dell'edificio
La manutenzione e gli interventi di assistenza periodica aiutano a preservare il valore del tessuto edilizio. E, come spesso accade, la soluzione è "informazione e comunicazione". Se gli abitanti sono sensibilizzati su come possono prendersi cura dell'edificio, molto è già stato fatto. Brigitte Tassenbacher aggiunge l'osservazione che oggi gli appartamenti o le case non sono più ventilati così spesso durante il giorno come un tempo, poiché entrambi i genitori sono spesso fuori dal lavoro. Dal suo punto di vista esperto, questo suggerisce anche l'installazione di un sistema di ventilazione meccanica controllata con recupero di calore e umidità, che rinnova regolarmente l'aria e regola anche l'umidità. In tutti i suoi anni di attività professionale, Brigitte Tassenbacher ha imparato più volte che la colpa della muffa da condensa è attribuita ai proprietari e che a volte sono anche deliberatamente intimiditi. È importante che tutte le parti coinvolte rimangano obiettive, dice, e che trovino ed eliminino insieme le cause ed eliminino la muffa in modo professionale.
Potrebbe interessarti anche:
Pompe di calore ad aria come funzionano, quanto si risparmia, vantaggi >>